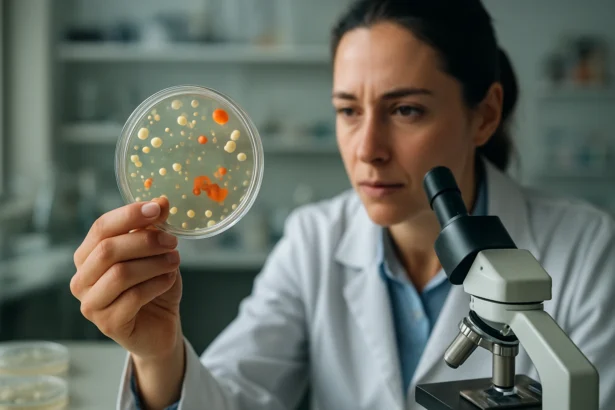
Vedkyňa skúma baktérie v petriho miske na laboratórnom stole.

Search
Must Read
© Foxiz News Network. Ruby Design Company. All Rights Reserved.
Značka: ekosystémy
Šokujúca pravda o celulóze: Kľúčový hráč v ekosystémoch, o ktorom ste netušili!
Celulóza nie je len stavebný prvok rastlín — je kľúčová v cykle uhlíka, tvorbe pôdy,…
14 Min Read
Šokujúce dôsledky znečistenia pôdy: Ako ohrozuje naše ekosystémy a zdravie?
Znečistenie pôdy ničí biodiverzitu, narušuje obeh živín, kontaminuje potraviny a podzemnú vodu a ohrozuje ľudské…
13 Min Read
Šokujúca pravda o baktériách: Ako malé organizmy formujú našu planétu a zabezpečujú fungovanie ekosystémov!
Objavte šokujúcu pravdu o baktériách: nenápadné mikroskopické tvory, ktoré formujú atmosféru, recyklujú živiny, podporujú rast…
14 Min Read